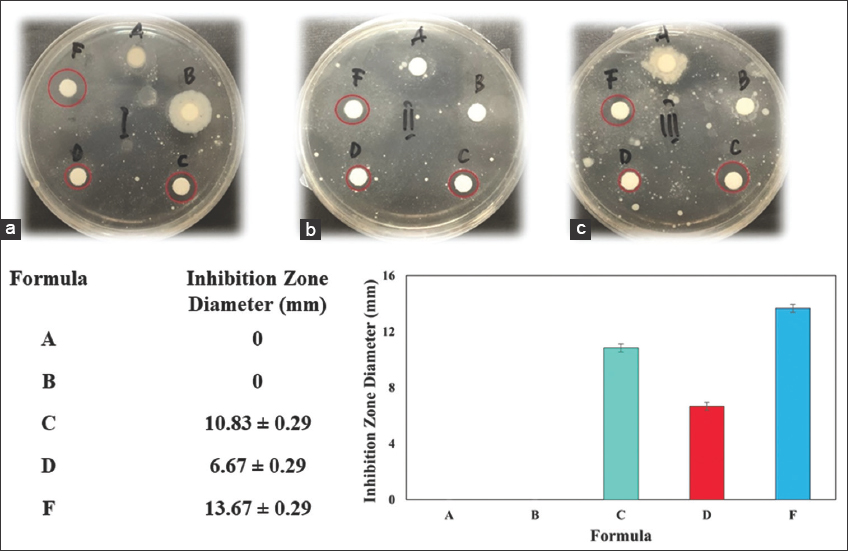

1. INTRODUCTION
Having clean and healthy skin is a desire shared by both men and women, although many individuals may experience skin problems such as acne [1]. With a global prevalence of 9.4%, acne is the world’s eighth most common disease, with approximately 80% of teenagers experiencing it [2].
Acne is a complex disorder caused by various factors, including genetics, racial, food, climate, skin type, hygiene, stress, infection, and work factors [2]. The development of acne is caused by the blockage of sebaceous follicles due to abnormal keratinization of the infundibular epithelium, leading to excess sebum production by androgens and inflammation triggered by the bacterium Propionibacterium acnes [3]. Clinical manifestations of acne include the presence of comedones, papules, pustules, nodules, and scarring, which can significantly affect an individual’s appearance [4].
Individuals may seek various methods to maintain healthy skin, including medical treatment, drug administration, or skin care products. Skin care involves cleaning, protecting, maintaining, and improving the skin’s condition to maintain its homeostasis [5]. Various acne facial skin care products, including serums, creams, acne patches, and face masks, are now available in the market. Among various types of face masks, sheet, clay, mud, peel-off, exfoliating, and sleeping masks are popular choices [6].
Conventional acne treatments include topical and oral medications. Topical medications, such as benzoyl peroxide, retinoids, and antibiotics, reduce inflammation, unclog pores, and kill bacteria [7]. However, topical treatments can cause skin irritation, dryness, and flakiness. Moreover, conventional treatments may not be effective for all types of acne or, in severe cases, require a combination of treatments and long-term use. Therefore, alternative treatments that are safe, effective, and well-tolerated are needed to address the limitations of conventional acne treatments [8].
In recent years, there has been a concerted effort to explore the green synthesis of AgNPs using Plantago major (Pm) as a bioreductor. These efforts have encompassed a wide range of techniques, solvents, and experimental conditions with the aim of exploiting the unique properties of these nanoparticles for various applications. Previous studies have meticulously characterized the resulting AgNPs, denoted as Pm-AgNPs, employing a range of spectroscopic and microscopic techniques [9]. In addition, the cytotoxicity and antibacterial activities of Pm-AgNPs have been rigorously assessed, highlighting their potential for therapeutic applications [10].
Studies have shown that AgNPs can effectively inhibit P. acnes, the bacteria responsible for acne formation [11].In addition, AgNPs have been found to possess anti-inflammatory properties, promote wound healing [12], and are safe to use on the skin. Many FDA-cleared products incorporate silver nanoparticle due to its proven antimicrobial properties and well-established safety profile for the skin [13]. A clinical study evaluating silver absorption from wound dressings found no adverse skin effects or systemic impact [14]. Furthermore, using plant extracts, such as Pm, in synthesizing AgNPs can offer additional benefits. Plant extracts contain bioactive compounds that can enhance the antimicrobial and anti-inflammatory properties of AgNPs as well as improve their stability and biocompatibility. Therefore, combining AgNPs and plant extracts can provide a safe and effective alternative for acne treatment, with minimal side effects and potential for resistance [10].
Our previous research represents a significant milestone in this investigation and presents a highly efficient and environmentally sustainable approach to synthesizing Pm-AgNPs. Optimization studies determined key parameters for synthesizing AgNPs from Pm leaves extract. The extract concentration and synthesis temperature were optimized for yield and particle size. Optimal conditions were a 0.25% extract concentration at 70°C. The resulting AgNPs had a spherical shape and diffractogram pattern similar to silver standards. These nanoparticles, characterized by a 10–20 nm size range, exhibited significant antibacterial activity against Staphylococcus aureus, Escherichia coli, and Pseudomonas aeruginosa at a concentration of 20 μg/mL. The outcomes of the study not only represent a significant ninefold increase in yields but also mark a substantial stride toward the broader therapeutic applications [9].
The current study builds on previous achievements [9] by pioneering the formulation of Pm-AgNPs into a facial sheet mask and evaluating its physical stability, safety, and efficacy. This study aims to offer a novel, safe, and effective solution for managing acne.
The sheet mask’s physical stability was tested using the freeze-thaw cycling test method for six cycles at extreme temperatures of 4°C and 40°C. The physical characteristics, such as organoleptic, homogeneity, pH, and viscosity, were observed to ensure it remained stable after six cycling tests [15]. The safety of the sheet mask was evaluated using a dermal irritation test on humans, the efficacy was evaluated microbiologically on P. acne, and the erythema and edema in healthy male white rats [16].
2. MATERIALS AND METHODS
2.1. Plant Materials and Chemicals
The plant materials used in this study included the dried leaves of Pm obtained from the Center for Research and Development of Medicinal and Traditional Medicinal Plants (B2P2TOT, Tawangmangu, Central Java, Indonesia). The plants were determined with the Certificate of Plant Identification number 1258/D.T/IX/2017). The dried leaves were powdered and sorted using a mixer and 20-mesh sorting.
2.2. Extraction
The dried leaf powder of Pm was extracted by Ultrasound-Assisted Extraction (UAE) using 50% ethanol as the solvent (solid-to-liquid ratio 1:10). The extraction was performed for 20 min with a frequency of 37 kHz. The extract was then filtered using a Whatman filter paper and stored at 4°C for further synthesis [9,17].
2.3. Synthesis of AgNPs using Pm Extract
The Pm extract was used as a raw material to synthesize AgNPs. The synthesis was carried out by mixing the extract with silver nitrate (Sigma-Aldrich, St. Louis, US) at a ratio of 1:1 and heated at 80°C for 30 min. The formation of AgNPs was confirmed by a color change from pale yellow to brownish-black. The procurement of the following chemicals was carried out from Merck (Darmstadt, Germany): Ethanol, sodium hydroxide, and potassium bromide of spectroscopy grade. All chemicals were of analytical grade except where specifically mentioned. Demineralized water was utilized in all procedures involving water [9,17].
2.4. Formulation of AgNPs Anti-acne Facial Sheet Mask
To formulate the anti-acne sheet mask, a homogeneous essence base (Formula A) was first prepared by mixing Hyaluronan 11 multi-complex (J2kBio, Chungbuk, Korea), Activonol-M and ActivNeo PEP (Activon, Chungcheongbuk-do, Korea) and CMCGel CGF (CM-Bridge, Gyeonggi-do, Korea). Active ingredients, including the aqueous extract of Pm leaves (Formula B), AgNPs (Formula C), and aqueous extract of Pm leaves combined with AgNPs (Formula D) were then added and stirred until homogeneous. The essence consisting of sodium diclofenac (Kimia Jaya Laboratory, Cilacap, Indonesia) (Formula E) and benzoyl peroxide (Viva apotek, Surabaya, Indonesia) (Formula F) was used as a positive control for the anti-inflammatory and anti acne test respectively.
To apply the essence to a dry sheet Tencel 40 M/S (CM-Bridge, Gyeonggi-do, Korea), 20 g of each essence was weighed and evenly distributed onto a dry sheet. The sheet mask containing the essence was packaged in sachet packs. The exact concentration of each formula can be found in Table 1.
Table 1: Essence formula for sheet mask.
| Component | Concentration (%) | |||||
|---|---|---|---|---|---|---|
| A | B | C | D | E | F | |
| Hyaluron 11 multi complex | 20.0 | 20.0 | 20.0 | 20.0 | 20.0 | 20.0 |
| CMCGel CGF | 20.0 | 20.0 | 20.0 | 20.0 | 20.0 | 20.0 |
| ActivNeo PEP | 3.0 | 3.0 | 3.0 | 3.0 | 3.0 | 3.0 |
| Activonol-M | 1.5 | 1.5 | 1.5 | 1.5 | 1.5 | 1.5 |
| Benzoyl peroxide | – | – | – | – | – | 0.5 |
| Sodium Diclofenac | – | – | – | – | 0.5 | – |
| AgNPs | – | – | 0.005 | 0.005 | – | – |
| Plantago major extract | – | 0.0247 | - | 0.0247 | – | – |
| Water | 55.5 | 55.00505 | 55.495 | 55.00005 | 55.0 | 55.0 |
2.5. Stability Testing of the Anti-acne Sheet Mask Under Freeze-thaw Conditions
A freeze-thaw method was employed to evaluate the sheet mask product’s stability. The product, packed in an aluminum sachet, was first placed in a refrigerator at 4°C for 24 h, then transferred to an oven set at 40°C for the next 24 h. This process is considered one cycle and was repeated for six cycles. Physical changes in the sheet mask product were observed at the beginning and end of each cycle. To assess the essence of the sheet mask, it was squeezed out and subjected to parameters such as organoleptic, pH, homogeneity, and viscosity. These parameters were used to determine any changes that may have occurred due to the freeze-thaw process [15].
2.6. Safety Evaluation of the Anti-acne Sheet Mask In Vivo Irritation Test
In this study, an irritation test was carried out to determine whether the anti-acne sheet mask containing AgNPs was synthesized using Pm was safe for use on males and females aged 20–25 skin. This test involved 15 human subjects, each receiving four types of sheet masks. The study protocol was approved by the Head of the Institutional Ethical Committee, University of Surabaya. The anti-inflammatory efficacy test was conducted with approval numbe (127A/KE/X/2022), while the irritation test was conducted approval number [66/KE/II/2023] by placing a sheet mask that had been cut to approximately 2.5 cm behind the ear and leaving it for 30 min. After 30 min, the sheet mask was removed, and the test area was cleaned with water to remove any remaining test material. Observations were conducted 24, 48, and 72 h after application of the sheet mask to assess the skin's reaction to the test substance. The skin was evaluated for the presence of erythema (redness) and edema (swelling), and scores ranging from 0 to 4 were assigned depending on the severity of the skin reaction [6].
2.7. Efficacy Assessment of the Anti-acne Sheet Mask against P. acnes
The efficacy of the anti-acne sheet mask against P. acnes was assessed microbiologically. P. acnes bacteria was provided by the Center for Health Laboratory (Balai Besar Laboratorium Kesehatan–BBLK, Surabaya, Indonesia), while Nutrient Agar media, Muller Hinton Agar media, Plate Count Agar media, Pepton Dilution Agar media, and 0.9% NaCl were purchased from Merck, Darmstadt, Germany. The test involved evaluating the anti-acne activity of five different essences: essence A (control base), essence B (containing Pm leaves extract), essence C (containing AgNPs), essence D (containing both Pm leaves extract and AgNPs), and essence E (containing Benzoyl peroxide as a positive control). The diameter of the inhibition zones surrounding the bacterial cultures of P. acnes was observed to determine the efficacy of each essence [16].
2.8. Evaluating the Anti-Inflammatory Efficacy of Sheet Mask Preparations
In this study, 25 healthy male white rats were prepared and acclimated for 10–14 days. After ensuring their weight was stable, the rats were randomly assigned to 5 groups of 5 rats each. All rats were fasted for 6 h and had their hair removed using a depilatory cream. A circular mark was made on the left hind leg of each rat, and the initial leg volume was measured using a plethysmometer. Then, all rats were injected with 0.5 mL of 1% ovalbumin solution. After 15 min of induction, each group of rats was given a different sheet mask formulation and placed on their backs for 90 min [16]. The anti-inflammatory efficacy test was conducted following ethical clearance number 127A/KE/X/2022.
3. RESULTS
Plant-based synthesis of nanoparticles is eco-friendly and produces biocompatible, non-toxic particles. Our previous work presented an efficient scale-up and eco-friendly synthesis method for 10–20 nm size of Pm-AgNPs that demonstrated notable antibacterial activity against S. aureus, E. coli, and P. aeruginosa at a concentration of 20 μg/mL. The results enable a ninefold increase in yields and are a significant step forward for further therapeutic and other applications.
Our current study aims to evaluate an anti-acne sheet mask’s safety, efficacy, and stability with AgNPs synthesized from Pm. We hypothesize that the mask will remain stable after freezing and thawing, safe, inhibit P. acnes growth, and reduce inflammation.
3.1. Physical Stability of the Anti-acne Sheet Mask under Freeze-thaw Conditions
The organoleptic evaluation results of the sheet mask essence in Table 2 showed that formula A was clear in appearance, odorless, and had a thick consistency. Formula B and D were brownish and opaque in appearance, odorless, and had a thick consistency. Formula C was observed to be a purplish-brown and clear liquid with a thick consistency and was also odorless. Formula E was white and opaque, odorless, and had a thick consistency. Furthermore, Figure 1, complementing the data presented in Table 1, provides visual confirmation of the consistent organoleptic properties of the sheetmask essence. It also illustrates that the essence of sheet mask products maintained homogeneity after six freeze-thaw cycles.
Table 2: Observed stability parameters of sheet mask’s essence before and after cycling test.
| Essence formula | Cycling test | Organoleptic | Homogenity | pH | Viscosity (cps) |
|---|---|---|---|---|---|
| A | Before CT | Viscous liquid, colorless, odorless | Homogenous | 5.25±0.01 | 309.6±1.58 |
| After 6 CT | 5.06±0.01 | 266.8±1.31 | |||
| B | Before CT | Viscous liquid, cloudy brown, odorless | Homogenous | 5.18±0.01 | 288.6±1,85 |
| After 6 CT | 5.00±0.00 | 251.4±1.66 | |||
| C | Before CT | Viscous liquid, purplish brown, odorless | Homogenous | 5.21±0.01 | 295.7±4.31 |
| After 6 CT | 5.02±0.00 | 255.5±2.27 | |||
| D | Before CT | Viscous liquid, cloudy brown, odorless | Homogenous | 5.20±0.01 | 282.6±2.05 |
| After 6 CT | 5.00±0.00 | 246.5±3.15 | |||
| E | Before CT | Viscous liquid, cloudy white, odorless | Homogenous | 5.05±0.00 | 284.6±1.62 |
| After 6 CT | 5.00±0.01 | 283.2±1.56 |
CT: Cycling test, cps: Centipoises. Each formula was made in three batches and each batch was measured in triplicate
 | Figure 1: Visual confirmation of the consistent organoleptic properties of the sheetmask essence base (formula A), with Plantago major (Pm) leaves extract (formula B), Pm-silver nanoparticles (AgNPs) (formula C), Pm leaves extract and Pm-AgNPs (formula D) in triplicate. [Click here to view] |
Figure 2a displays the results of viscosity measurements for formulations A, B, C, and D, with an average viscosity range of 246.5–309.6 centipoises. The flow behavior of the sheetmasks was characterized by a non-Newtonian pseudoplastic flow. Notably, repeated temperature stress cycles resulted in a noticeable reduction in the viscosity of the essence across four formulations. Figure 2b shows that the pH of the sheet mask essence is within the standard requirement for facial mask preparations, ranging from 5.00 to 5.2. These results correspond to the recommended pH range of 4.5–6.5, indicating the suitability of the formulations for facial mask application [6].
 | Figure 2: Viscosity (a) and pH (b) of sheet mask essence at various formulations before (0) and during the six freeze-thaw cycle stability tests. The results are the mean ± standard deviation of three measurements. Viscosity stability was measured using a brookfield viscometer and pH stability was measured using a pH meter. [Click here to view] |
3.2. The Safety Profile of the Anti-acne Sheet Mask From In Vivo Irritation Test
The irritation effect was assessed at 0 h before applying sheet masks containing essence, 30 min after the sheet masks were applied and cleaned with water, and 24, 48, and 72 h after the test material was released. Before applying the sheet masks to the skin area behind the ear, observations were made to ensure no other factors were affecting the area besides the sheet mask. The severity scores of erythema and edema in the subjects’ skin behind the ear after applying sheet masks A, B, C, and D at 24, 48, and 72 h were zero (0). The results of the irritation test visualization, as shown in Figure 3, indicated that the anti-acne sheet mask was well-tolerated and did not cause any significant skin irritation or adverse reactions in the test subjects. No erythema or edema was observed during the observation period, and no complaints of burning or stinging sensation, suggesting that the sheet mask was safe for use on the skin. These findings support the safety of the anti-acne sheet mask containing AgNPs synthesized using Pm as a topical treatment for acne vulgaris.
 | Figure 3: Visualization of irritation test results of four formulations at (a) Pre-application assessment, (b) assessment during sheet mask application, and (c) assessment after 30 min of application. The anti-acne sheet mask demonstrated excellent skin tolerance, with no observable signs of erythema or edema throughout the observation period of (d) 24 h, (e) 48 h, and (f) 72 h post-application. [Click here to view] |
3.3. Efficacy of the Anti-acne Sheet Mask against P. acne
The antibacterial test against P. acnes was conducted using the disc diffusion method to assess the ability of the test sample to inhibit P. acnes growth. The diameter of the inhibition zone can be seen in Figure 4.
| Figure 4: (a-c) Antibacterial activity against Propionibacterium acnes. Formulas A and B showed no inhibition zones. Formula C, with silver nanoparticles (AgNPs), displayed a 10.83 ± 0.29 mm inhibition zone. Formula D, combining Plantago major leaf extract and AgNPs, showed a smaller zone (6.67 ± 0.29 mm) than formula C. The positive control, benzoyl peroxide (formula F), showed a 13.67 ± 0.29 mm zone. [Click here to view] |
Figure 4 visualizes that formulas A and B produced no clear zones, indicating no inhibition against P. acnes bacteria. Formula A (negative control) did not produce any inhibition zones as it only contained the base without antibacterial properties. Formula B, contains the active ingredient of water extract of Pm leaves, did not produce any inhibition zone. However, formula C, containing AgNPs as the active ingredient, showed a clear inhibition zone with a diameter of 10.83 ± 0.29 mm. Formula D, containing water extract of Pm leaves combined with AgNPs, had a smaller inhibition zone (6.67 ± 0.29 mm) than formula C. The positive control was benzoyl peroxide (Formula F) with an inhibition zone diameter of 13.67 ± 0.29 mm, which was effective in inhibiting P. acnes bacteria and used to treat mild to moderate acne [7]. The formation of inhibition zones in formulas C and D was due to AgNPs in the essence formula.
3.4. Efficacy of the Anti-acne Sheet Mask in Reducing Inflammation
The animal used in this study for testing anti-inflammatory activity was male Wistar white rats weighing between 200 g and 250 g. Rats were chosen for this test as they have a suitable weight range for the study, and their larger leg volume makes it easier to observe changes in edema volume using a plethysmometer. Inflammation on the rat’s legs was induced by subcutaneously administering 1% ovalbumin to the left hind paw, and the intensity of inflammation was measured by observing changes in the leg volume using a plethysmometer. The percentage of inhibition of inflammation for all treatment groups was calculated by comparing the edema volume and time of observation for each rat in each treatment group. The profile of the average edema volume in the function of time in the application of sheet masks are shown in Figure 5.
 | Figure 5: The profile of the average edema volume in the function of time in the application of sheet mask with the formulation groups without active ingredients (A), containing water extract of Plantago major (Pm) (B), containing silver nanoparticles (AgNPs) synthesis of Pm water extract (C), a formulation containing AgNPs with the addition of Pm water extract (D), and a positive control containing sodium diclofenac (E). [Click here to view] |
The results showed no decrease in the average edema volume observed at any time point in treatment group A, which was the negative control. This was different from treatment groups C, D, and E, which showed a decrease in average edema volume starting at 45 min. At 30 min, treatment group A showed an increase in average edema volume, whereas treatment groups B, C, D, and E did not show an increase and tended to be more constant. This was because treatment group A did not receive any active ingredient that could inhibit edema formation or act as an anti-inflammatory. Therefore, there was an increase in average edema volume at 30 min, and no significant decrease in average edema volume was observed at any time point except at 75 and 90 min. The decrease in average edema volume at 75 and 90 min observed in treatment group A was suspected to be a physiological homeostatic response in rat’s body to reduce inflammation. Meanwhile, treatment groups B, C, D, and E showed anti-inflammatory activity, indicated by a decrease in average edema volume.
The average decrease in edema volume from treatment groups B, C, D, and E indicates different rates and magnitudes of average edema volume reduction. At min 45, treatment groups C, D, and E had already experienced a reduction, which is different from treatment group B, which had not yet reduced but was more constant due to the concentration of Pm water extract used being 0.02475%. In comparison, the optimum concentration of Pm water extract for anti-inflammatory activity is 10%, indicating that the anti-inflammatory activity is not optimal in reducing the average edema volume [16].
Meanwhile, the average decrease in edema volume in treatment groups C, D, and E shows a significant difference in magnitude at min 60. Still, there is no significant difference in reducing the average edema volume at min 75 or 90. Treatment group D shows a slightly smaller average edema volume reduction value at min 60, which is 0.018, compared to treatment groups C and D, which offer a somewhat more significant average edema volume reduction at min 60 of 0.016 and 0.014, respectively. Treatment group B, on the other hand, shows a much lower average edema volume reduction than treatment groups C, D, and E.
The Tukey test showed an insignificant difference in reducing edema volume among treatment groups C, D, and E. Therefore, it can be concluded that treatment groups C, D, and E provide equal anti-inflammatory activity and are superior to treatment groups A and B. It can also be concluded that sheet mask preparations containing AgNPs synthesized from Pm leaves water extracts have an anti-inflammatory activity of 58% on rat feet induced with 1% ovalbumin, as shown in Table 3. The sheet mask preparations containing AgNPs synthesized from water extracts of Pm leaves showed a much greater anti-inflammatory activity (% inflammation inhibition) than base-containing sheet mask preparations (negative control).
Table 3: The area under the curve and percentage of inflammation inhibition in male Wistar white rat groups when using various formulations of sheet masks.
| Formulation group | Average AUC±SD | Inhibition of inflammation (%) |
|---|---|---|
| A | 3.945±0.64 | 0 |
| B | 2.595±0.16 | 34 |
| C | 1.725±0.41 | 56 |
| D | 1.665±0.43 | 58 |
| E | 1.875±042 | 53 |
Pm: Plantago major, (AgNPs: Silver nanoparticles, AUC: Area under curve, SD: Standard deviation, Male Wistar white rat groups in the application of sheet masks without active ingredients (A), extract of Pm (B), Pm-AgNPs (C), Pm-AgNPs with the addition of Pm extract (D), and a positive control containing sodium diclofenac (E). Each formula was made in three batches and each batch was measured in triplicate
4. DISCUSSION
The use of AgNPs synthesized using Pm leaves extracts in anti-acne sheet masks can be rationalized based on the antibacterial benefits of both AgNPs and Pm leaf extracts. Acne is caused by bacteria such as Staphylococcus epidermidis, S. aureus, and P. acnes [17]. Both AgNPs and Pm leaf extracts have been shown to have antibacterial activity against these bacteria. AgNPs can damage bacterial cell walls, leading to structural changes in the cell membrane and, ultimately, cell death [12]. Pm leaf extracts contain compounds such as tannins, aucubin, and flavonoids, which have been found to have antibacterial effects by denaturing amino acids and enzymes of the P. acnes bacteria and inhibiting bacterial replication [16]. Furthermore, the use of sheet masks as a medium for delivering the AgNPs and Pm leaf extracts has the advantage of good absorption and penetration profiles, as well as efficient and hygienic packaging [6].
Pm as a natural source for synthesizing AgNPs offers several advantages. It is readily available, cost-effective, and environmentally friendly, as the green synthesis method reduces the use of hazardous materials [12]. The plant’s natural compounds provide a safe means of reducing and stabilizing AgNPs. Moreover, the resulting AgNPs have shown strong antibacterial properties against acne-causing bacteria, making them a promising alternative to conventional treatments [9,18].
The essence of all sheet mask products remain stable without any changes in appearance, color, or odor during the six freeze-thaw cycles. Maintaining an appropriate pH is crucial to prevent the negative effects. Excessively acidic pH can cause skin irritation and tissue damage. In contrast, excessive alkaline pH can cause the skin to become scaly due to the damage to the acid mantle on the stratum corneum [19].
The storage of sheet mask products at extreme temperatures from cycles 0 to 6 did not show any organoleptic changes, indicating the stability of the product. The homogeneity of the sheet mask product was achieved through precise mixing and stirring by the researcher, resulting in homogeneity from cycles 0 to 6. The viscosity of formula A was higher compared to formulas B, C, and D, potentially due to the effect of the active ingredient added to formulas B, C, and D. However, the decrease in viscosity was not too extreme and still met the requirement of 230–1150 cPs. The viscosity decrease in each formula could be overcome by using carbomer as a thickener and stabilizer in the base. The pH testing results over six cycles showed changes with increasing storage time, which was generally caused by the hydrolysis of acidic compounds in the product. However, the pH values were still within the safe criteria for skin, which is between 4.5 and 6.5 [19]. One-way Analysis of Variance statistical tests on the pH for each formula from cycle 0 to 6 indicated no significant differences (P > 0.05), suggesting that formula differences did not affect the pH stability of the sheet mask product. The pH decrease in each formula could potentially be overcome by using potassium hydroxide or triethanolamine to maintain pH stability.
In this study, irritation testing was conducted on fifteen subjects of males and females aged 20–25. The choice of subjects within this age range is relevant since acne is a prevalent skin issue among adolescents aged 20–29, affecting approximately 50.9% of women and 42.5% of men [20]. The active irritation test material consisted of water extract of Pm leaves and AgNPs. Testing without the active ingredient was also conducted to assess the potential irritation caused by the sheet mask and the basis of the essence. The test material was applied to the skin behind the ear because it is sensitive and allows easy observation of any irritation effect [21]. The skin behind the ear possesses a thin stratum corneum in the epidermis layer, enhancing material absorption while minimizing sheet mask movement to prevent detachment. A tencel-based sheet mask with a diameter of 2.5 cm was employed to conduct the attachment. It is crucial to mention that when the human skin barrier function is disturbed, AgNPs can penetrate the skin. AgNPs at concentrations ranging from 0.2% to 2% have been observed to penetrate the skin without exhibiting any toxicity [22]. Therefore, a concentration of 0.005% was used in the tested sheet mask essence formulation. In addition, the size of the AgNPs used was 181.5 nm, and at a size of 20–200 nm, when in contact with healthy or damaged skin, they cannot penetrate the skin barrier and penetrate deeper layers, making them safe to use as cosmetics [22]. Furthermore, the ingredients in the sheet mask essence are registered on the Material Safety Data Sheet, providing an added safety assurance.
Observations of irritation effects were conducted at 0 h before the sheet mask containing the essence was attached, 30 min after the sheet mask was applied and cleaned with water, and 24, 48, also 72 h after the test material was removed. Before the skin area behind the ear was applied with the sheet mask, it needed to be observed to ensure there were no other influencing factors except for the applied sheet mask. Based on irritation testing, sheet mask preparations A, B, C, and D did not cause skin irritation such as erythema, edema, or complaints of burning or stinging sensations. Hence, these preparations are considered safe for use.
According to the study by George et al., AgNPs are safe for skin application as they do not enter systemic circulation, implying no potential end-organ effects after 5 days of application. The study found that AgNPs can penetrate intact human skin in vivo beyond the stratum corneum and can be found as deep as the reticular dermis. However, there is no detectable increase in serum silver levels post-treatment with the silver dressing [14]. These findings are consistent with other studies that have reported the safe use of silver materials, including AgNPs, in skin formulations. Silver materials are currently used as main ingredients in several FDA-cleared and marketed skin products due to their unique antimicrobial properties and widely accepted skin safety profiles. Similarly, a clinical study evaluated the silver absorption from silver-containing wound dressings for potential systemic effects in subjects and found no adverse skin effects [13].
Previous studies have shown that AgNPs in water extract of Pm leaves have antibacterial activity against both gram-positive and gram-negative bacteria [9]. AgNPs have a small size and a large surface area, allowing them to contact microorganisms very effectively. AgNPs’ antibacterial agent mechanism involves diffusion, where AgNPs approach the bacterial cell membrane and penetrate the bacteria [17]. The particles then interact with phosphorus and sulfur in DNA, causing damage to the microbial cell. This interaction results in DNA losing its ability to replicate, preventing cell division and microbial growth, ultimately causing the cell to die [23].
The formation of inhibition zones in formulas C and D was due to the presence of AgNPs in the essence formula. Compared to previous studies [6] that investigated the antibacterial activity of AgNPs in acne cream and resulted in a 0.75 mm inhibition zone, the essence sheet mask formulas C and D had a more significant inhibition zone. Therefore, formulas C and D are effective in anti-acne treatment.
The ingredients in the sheet mask’s essence are hyaluronan 11 multi-complex, which has the function of increasing skin hydration, maintaining skin elasticity, reducing skin damage caused by external stress, lubricating the skin so that the main components like collagen can be easily transported between cells, and retaining water or moisture within the skin. Moisturizers can help maintain, restore, and repair damaged skin and skin elasticity by preventing moisture evaporation, inducing the shedding of dead skin cells, and directly carrying out uniform tissue regeneration or repair to maintain a smooth skin surface. It can also restore the ability of the lipid bilayer between cells to absorb, retain, and redistribute water, thereby increasing skin hydration and increasing the water content of the stratum corneum by directly providing water to the skin from its water phase and increasing occlusion to reduce trans-epidermal water loss [6]. The next ingredient is CMGel CGF, a synthetic polymer base used as a binder. Activonol-M is a preservative, while ActivNeo PEP is an anti-aging agent.
This study’s strengths lie in using sustainable, eco-friendly ingredients for AgNP synthesis, comprehensive evaluation of safety and efficacy, employing both in vitro and in vivo experiments, and valuable insights for a new natural-based anti-acne facial sheet mask.
Recent therapeutic and cosmetic developments have greatly expanded the potential applications of AgNPs. Takác et al. have highlighted the pivotal role of AgNPs in cancer nanomedicine. Their study underlines the versatility of AgNPs, which can be synthesized using a suitable low-cost green synthesis technique, and demonstrated the potential of AgNPs to inhibit cancer cell growth and viability, induce apoptosis and necrosis, and suppress tumor cell migration and angiogenesis. The multifaceted attributes of AgNPs, such as their antibacterial, antiviral, antifungal, and anti-inflammatory properties, have generated considerable interest. Their integration into various nanocomposite products, cosmetics, and food processing applications has been observed. AgNPs demonstrate high chemical consistency, excellent biocompatibility, low toxicity, and are environment-friendly, thus solidifying their role in modern applications [24].
Ghazwani et al. (2023) developed a ultra violet (UV)-protective sunscreen gel utilizing methyl-anthranilate-loaded AgNPs (MA-AgNPs). Their findings demonstrate that the response surface methodology optimized MA-AgNPs offer substantial advantages over conventional methyl-anthranilate formulations, particularly in topical delivery of methyl anthranilate. This advancement represents a significant step forward in enhancing the efficacy and safety of UV-protective formulations, underscoring the potential of AgNPs in sunscreens and dermatological applications [25].
4.1. Limitations
Limitations of the study include the lack of assessment of long-term safety of the anti-acne facial sheet mask and the absence of investigation into its mechanism of action. Furthermore, the study did not compare the efficacy of the anti-acne facial sheet mask with other commercially available anti-acne facial sheet masks.In addition, the effects of the anti-acne facial sheet mask on different skin types or conditions other than acne were not explored.
5. CONCLUSION
In conclusion, the study demonstrated that an anti-acne sheet mask containing AgNPs synthesized using Pm was physical stable and safe to use. It did not cause significant skin irritation or adverse reactions. The formula was effective in inhibiting P. acnes bacteria and could be used to treat mild to moderate acne. Furthermore, sheet mask preparations containing AgNPs synthesized from water extracts of Pm leaves demonstrate anti-inflammatory activity. These findings support the potential use of natural and eco-friendly ingredients, such as Pm in developing safe and effective anti-acne products.
6. AUTHOR CONTRIBUTIONS
Christina Avanti contributed to conceptualization, data analysis, manuscript drafting, supervision, and final approval. Apriliana Muftilana contributed to data analysis, interpretation of data, and admin. Bella Fiesta contributed to data analysis, interpretation data, and admin. Karina Citra Rani contributed to data acquisition and statistical analysis. Johan Sukweenadhi contributed to drafting, critical manuscript revision, and statistical analysis. Kartini contributed to data analysis and interpretation data. Ricky Gonzali Mago and Wahyu Vinovia Devi contributed to data acquisition and administration. Devyani Diah Wulansari contributed to data analysis, statistical analysis, and administration. Aguslina Kirtishanti contributed to data acquisition, supervision, and final approval.
7. ACKNOWLEDGMENT
This research was supported by a grant from the Ministry of Research and Technology/National Research and Innovation Agency of the Republic of Indonesia (contract number 023/SP-Lit/LPPM-01/RistekBRIN/Mono/FF/III/2021).
9. CONFLICTS OF INTEREST
The authors report no financial or any other conflicts of interest in this work.
10. ETHICAL APPROVALS
The study protocol was approved by the Head of the Institutional Ethical Committee, University of Surabaya. The anti-inflammatory efficacy test was conducted with approval number (127A/KE/X/2022), while the irritation test was conducted with approval number [66/KE/ II/2023].
11. DATA AVAILABILITY
All data generated and analyzed are included within this article.
12. PUBLISHER’S NOTE
All claims expressed in this article are solely those of the authors and do not necessarily represent those of the publisher, the editors and the reviewers. This journal remains neutral with regard to jurisdictional claims in published institutional affiliation.
13. USE OF ARTIFICIAL INTELLIGENCE (AI)-ASSISTED TECHNOLOGY
The authors declares that they have not used artificial intelligence (AI)-tools for writing and editing of the manuscript, and no images were manipulated using AI.
REFERENCES
1. Heng AH, Chew FT. Systematic review of the epidemiology of acne vulgaris. Sci Rep 2020;10:5754. [CrossRef]
2. Tan JK, Bhate K. A global perspective on the epidemiology of acne. Br J Dermatol 2015;172 Suppl 1:3-12. [CrossRef]
3. Dréno B, Pécastaings S, Corvec S, Veraldi S, Khammari A, Roques C. Cutibacterium acnes (Propionibacterium acnes) and acne vulgaris:A brief look at the latest updates. J Eur Acad Dermatol Venereol 2018;32 Suppl 2:5-14. [CrossRef]
4. Davis EC, Callender VD. A review of acne in ethnic skin:Pathogenesis, clinical manifestations, and management strategies. In J Clin Aesthet Dermatol 2010;3:24-38.
5. Rodan K, Fields K, Majewski G, Falla T. Skincare bootcamp:The evolving role of skincare. Plast Reconstr Surg Glob Open 2016;4:e1152. [CrossRef]
6. Nilforoushzadeh MA, Amirkhani MA, Zarrintaj P, Moghaddam AS, Mehrabi T, Alavi S, et al. Skin care and rejuvenation by cosmeceutical facial mask. J Cosmet Dermatol 2018;17:693-702. [CrossRef]
7. Oge'LK, Broussard A, Marshall MD. Acne vulgaris:Diagnosis and treatment. Am Fam Physician 2019;100:475-84.
8. Tobiasz A, Nowicka D, Szepietowski JC. Acne vulgaris-novel treatment options and factors affecting therapy adherence:A narrative review. J Clin Med 2022;11:7535. [CrossRef]
9. Sukweenadhi J, Setiawan KI, Avanti C, Kartini K, Rupa EJ, Yang DC. Scale-up of green synthesis and characterization of silver nanoparticles using ethanol extract of Plantago major L. Leaf and its antibacterial potential. S Afr J Chem Eng 2021;38:1-8. [CrossRef]
10. Liao C, Li Y, Tjong SC. Bactericidal and cytotoxic properties of silver nanoparticles. Int J Mol Sci 2019;20:449. [CrossRef]
11. Artounian K, Bundogji N, Hoss E, Boen M. Applications of gold and silver nanoparticles in the treatment of acne vulgaris:A systematic review. J Drugs Dermatol 2021;20:666-70.
12. Salve P, Vinchurkar A, Raut R, Chondekar R, Lakkakula J, Roy A, et al. An evaluation of antimicrobial, anticancer, anti-inflammatory and antioxidant activities of silver nanoparticles synthesized from leaf extract of Madhuca longifolia utilizing quantitative and qualitative methods. Molecules 2022;27:6404. [CrossRef]
13. Husain S, Nandi A, Simnani FZ, Saha U, Ghosh A, Sinha A, et al. Emerging trends in advanced translational applications of silver nanoparticles:A progressing dawn of nanotechnology. J Funct Biomater 2023;14:47. [CrossRef]
14. George R, Merten S, Wang TT, Kennedy P, Maitz P. In vivo analysis of dermal and systemic absorption of silver nanoparticles through healthy human skin. Australas J Dermatol 2014;55:185-90. [CrossRef]
15. Cekic ND, Savic SM, Savic SD. Dynamic-mechanical thermoanalysis test:A rapid alternative for accelerated freeze-thaw stability evaluation of W/O emulsions. Drug Dev Ind Pharm 2019;45:1896-906. [CrossRef]
16. Ryu S, Han HM, Song PI, Armstrong CA, Park Y. Suppression of Propionibacterium acnes infection and the associated inflammatory response by the antimicrobial peptide P5 in Mice. PLoS One 2015;10:e0132619. [CrossRef]
17. Kim JS, Kuk E, Yu KN, Kim JH, Park SJ, Lee HJ, et al. Antimicrobial effects of silver nanoparticles. Nanomedicine 2017;3:95-101. [CrossRef]
18. Shah MZ, Guan ZH, Din AU, Ali A, Rehman AU, Jan K, et al. Synthesis of silver nanoparticles using Plantago lanceolata extract and assessing their antibacterial and antioxidant activities. Sci Rep 2021;11:20754. [CrossRef]
19. Lambers H, Piessens S, Bloem A, Pronk H, Finkel P. Natural skin surface pH is on average below 5, which is beneficial for its resident flora. Int J Cosmet Sci 2006;28:359-70. [CrossRef]
20. Collier CN, Harper JC, Cafardi JA, Cantrell WC, Wang W, Foster KW, et al. The prevalence of acne in adults 20 years and older. J Am Acad Dermatol 2008;58:56-9. [CrossRef]
21. Noga M, Milan J, Frydrych A, Jurowski K. Toxicological aspects, safety assessment, and green toxicology of silver nanoparticles (AgNPs)-critical review:State of the art. Int J Mol Sci 2023;24:5133. [CrossRef]
22. Ong WT, Nyam KL. Evaluation of silver nanoparticles in cosmeceutical and potential biosafety complications. Saudi J Biol Sci 2022;29:2085-94. [CrossRef]
23. McLaughlin J, Watterson S, Layton AM, Bjourson AJ, Barnard E, McDowell A. Propionibacterium acnes and acne vulgaris:New insights from the integration of population genetic, multi-omic, biochemical and host-microbe studies. Microorganisms 2019;7:128. [CrossRef]
24. Takáv P, Michalková R, CižmárikováM, Bedlovivová Z, Balážovác, Takácová G. The role of silver nanoparticles in the diagnosis and treatment of cancer:Are there any perspectives for the future?Life (Basel) 2023;13:466.
25. Ghazwani M, Hani U, Alqarni MH, Alam A. Development and characterization of methyl-anthranilate-loaded silver nanoparticles:A phytocosmetic sunscreen gel for UV protection. Pharmaceutics 2023;15:1434. [CrossRef]